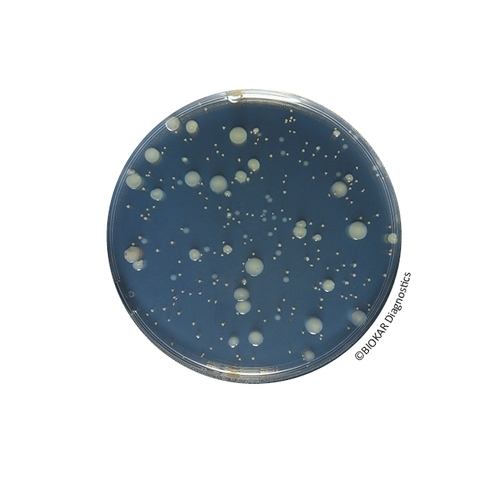
Yeast Extract Agar

Yeast Extract Agar
Yeast Extract Agar is used in water microbiology for the enumeration of culturable microorganisms by colony count at 36 and 22°C. The method is intended to measure the functional efficiency of drinking water treatment, and more generally, all types of water. It is particularly well adapted to the analysis of water destined for human consumption, including bottled and natural mineral waters and swimming pool water.
| Ürün Adı | Yeast Extract Agar |
| Ürün Kodu | BM06808 |
| Miktar | 10 vials of 200 mL |
TECHNICAL DATA SHEET
TDS_YEAST EXTRACT AGAR_BK153_BM068_ENv6